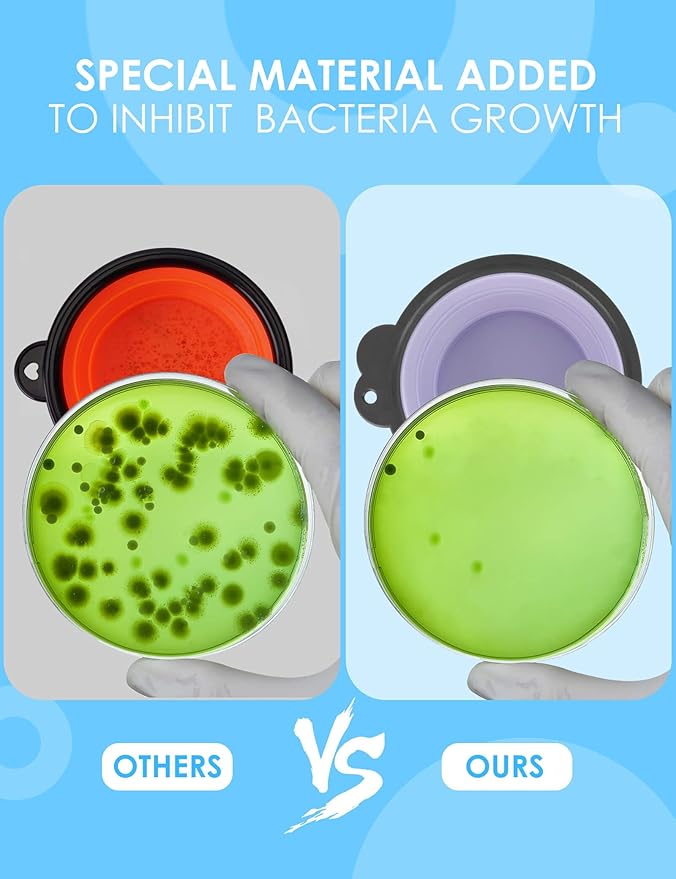

AONKEY
Aonkey Collapsible Dog Bowls with Bottle Carrier, 2 Pack Travel Dog Water Bowl Upgraded Carabiner, One-Piece Molded Rim No Fall Off or Crack, Foldable Silicone Portable for Pets Walking Hiking 37oz
Aonkey Collapsible Dog Bowls with Bottle Carrier, 2 Pack Travel Dog Water Bowl Upgraded Carabiner, One-Piece Molded Rim No Fall Off or Crack, Foldable Silicone Portable for Pets Walking Hiking 37oz
Couldn't load pickup availability
About This
- 【Unique and Different】Aonkey dog bowl set is in a league of its own, addressing issues from feedback on other bowls. The upgraded carabiner boasts a larger, sturdier opening, reducing the risk of breakage. Plus, enjoy the added convenience of bottle carriers, compatible with most cola-shaped water bottles in the market.
- 【Revolutionary Structure】Say goodbye to the hassle of assembled plastic rings. Aonkey's foldable dog bowl boasts an upgraded structure, integrating soft silicone with a hard rim. No more worries about the ring coming off or cracking, and the clip hole remains intact.
- 【Unmatched Stability】Thanks to the integrated hard rim, our dog bowl stays sturdy when unfolded. No more spills or losing structure. Carry it confidently with one hand, even when it's full of water.
- 【Perfect for On-the-Go】These travel bowls are a breeze to pack since they collapse effortlessly. Clip them to a backpack or water bottle – ideal for outgoing to the park, hiking, driving, or any social activities with your furry friend.
- 【Safety First】Crafted from high-quality, food-grade silicone with a tempting beef flavor, our dog foldable bowl eliminates the typical silicone smell that dogs dislike. BPA-free, dishwasher safe, it's not just convenient but also healthy for your pet.
Overview
- Material : Silicone
- Target Species : Dog
- Brand : AONKEY
- Recommended Uses For Product : Hiking
- Special Feature : Collapsible, Food Grade Material, Long-lasting, Portable
Share






Blog & Tips
-

Creating Cozy Spaces: The Power of Soft Comfort...
Find out how cozy beds and soft accessories from PetLovers nurture your dog's true comfort and happiness. Comfort is care with PetLovers.
Creating Cozy Spaces: The Power of Soft Comfort...
Find out how cozy beds and soft accessories from PetLovers nurture your dog's true comfort and happiness. Comfort is care with PetLovers.
-

Home-to-Outdoors: Creating Calming Transitions ...
Help your dog feel calm and secure when heading outside. Practical tips and comforting gear from PetLovers for soothing home-to-outdoor transitions.
Home-to-Outdoors: Creating Calming Transitions ...
Help your dog feel calm and secure when heading outside. Practical tips and comforting gear from PetLovers for soothing home-to-outdoor transitions.
-

Unlocking Calm at Home: Creating a Serene Space...
Learn how to create a calming home for your dog with PetLovers. Discover tips for stress-free spaces, cozy beds, and emotional wellness.
Unlocking Calm at Home: Creating a Serene Space...
Learn how to create a calming home for your dog with PetLovers. Discover tips for stress-free spaces, cozy beds, and emotional wellness.
-

Daily Rituals for a Calm and Happy Dog: PetLove...
Soothe your dog's anxiety with daily rituals from PetLovers. Learn calming routines for a joyful, well-balanced pet. Discover more now.
Daily Rituals for a Calm and Happy Dog: PetLove...
Soothe your dog's anxiety with daily rituals from PetLovers. Learn calming routines for a joyful, well-balanced pet. Discover more now.
Do you offer international shipping?
Orders usually arrive within 3–5 business days within the U.S
Currently, we only ship within the United States.
Yes, returns are accepted within 30 days of delivery, as long as the product is unused and in original condition.
- Our customer support team is available 24/7 to assist you.
- Email: petlovershelpdesk@gmail.com
- ☎ Phone: (951) 417-6767
- We aim to respond to all inquiries within 24 hours